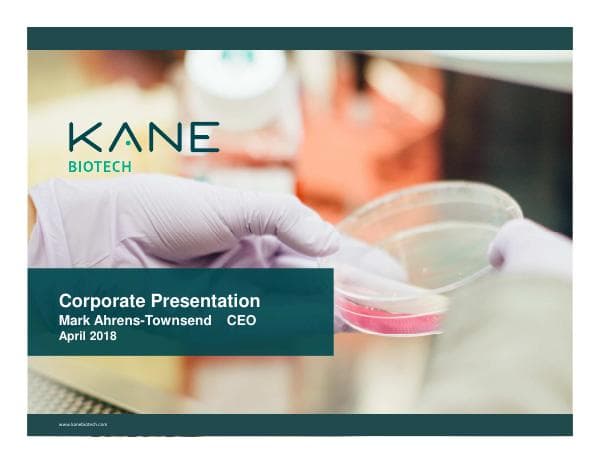
Kane+Biotech-Corporate+Investor+Presentation-Apr+2018

012e6dbe-4df1-4fca-9b8e-05e9bf9728d4
Loading viewer...
presentation
Format: PDF presentation
012e6dbe-4df1-4fca-9b8e-05e9bf9728d4 by Chevron.
Loading viewer...
presentation
Format: PDF presentation
012e6dbe-4df1-4fca-9b8e-05e9bf9728d4 by Chevron.

infographic

presentation
Advanced Emissions Solutions

presentation
DHL

presentation
Green Brick Partners
presentation
Bridge Investment Group